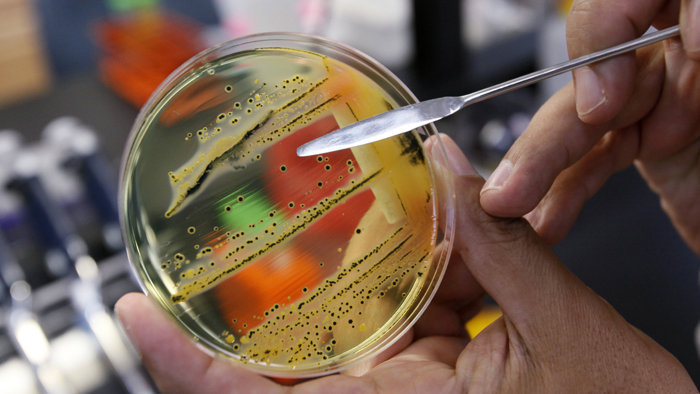
анализ кала

Зудящие ощущения в области ануса доставляют массу неприятностей, и значительно снижают качество жизни. Если у ребенка чешется в заднем проходе, важно своевременно установить причину зуда, и принять меры для ликвидации проявлений.
Дети, владеющие речевыми навыками, сами расскажут о тех не комфортных ощущениях, которые их беспокоят.
Малышам, в таких ситуациях, свойственно:
Младенцы первого года жизни становятся капризными и плаксивыми. Понять, почему у ребенка изменилось поведение, можно при внимательном осмотре. Раздражение вокруг ануса, может быть причиной беспокойства, и симптомом заболевания.
Причины зуда

Зуд в попе может быть спровоцирован разными причинами, для дифференциации которых необходимо обратиться за врачебной помощью. Во избежание осложнений не следует заниматься самолечением.
В педиатрической практике выделяют следующие причины, вызывающие зудящие ощущения:
Иногда, зуд может возникнуть, как неспецифическая реакция на неблагоприятное для малыша психологическое воздействие (стрессовая ситуация).
Чешение в области заднего прохода у детей может быть вызвано различными факторами, и врачи подчеркивают важность внимательного подхода к этой проблеме. Одной из наиболее распространенных причин является наличие глистов, таких как острицы, которые вызывают зуд, особенно ночью. Также врачи отмечают, что аллергические реакции на продукты питания или средства гигиены могут приводить к раздражению кожи. Неправильная гигиена, недостаточная чистота или, наоборот, чрезмерное использование мыла могут усугубить ситуацию. Важно, чтобы родители не игнорировали этот симптом и обращались к специалисту для диагностики и назначения соответствующего лечения. Правильный подход поможет устранить дискомфорт и предотвратить возможные осложнения.
https://youtube.com/watch?v=Ii4uXrhCDGQ
Гельминты

У детей проникновение гельминтов в организм (глистная инвазия) осуществляется, чаще всего, оральным способом, то есть через ротовую полость. Это связано с неосознанной привычкой малышей облизывать руки, пробовать «на зуб» игрушки и другие предметы. Паразиты, временно живущие, на предметах гигиены и быта, в грунте, шерсти животных, попадают на руки ребенка, а затем, в рот.
Самым распространенным видом гельминтоза среди детей является энтеробиоз. Возбудитель болезни – круглый червь (острица), в 90% случаев попадает в детский организм из-за пренебрежения правилами личной гигиены. Яйца паразита проникают в тонкий кишечник, где вырастают и активно размножаются. Оплодотворенная самка остриц ночью выползает через анус и откладывает в перианальной области больше 5000 яиц.
Обосновавшись в складках прямой кишки и анального отверстия, яйца вызывают зуд. У ребенка сильно чешется попа, и он непроизвольно трет анус. При этом яйца остриц остаются на коже, под ногтями. Прикасаясь немытыми руками к продуктам, малыш заражается повторно. Кроме того, предметы и продукты, с которыми контактировал ребенок, становятся потенциально опасными для окружающих. Паразиты данного вида чрезвычайно живучи в окружающей среде.
Признаки гельминтной инвазии
Инкубационный период энтеробиоза длится от 20 до 40 дней.
При инфицировании острицами у детей наблюдаются следующие симптомы:
Ребенка постоянно беспокоят режущие боли, жжение в области прямой кишки (тенезмы).
Чешение в области заднего прохода у детей — распространенная проблема, о которой часто говорят родители. Многие связывают это с возможными аллергиями на продукты питания или средствами гигиены. Некоторые считают, что причина может быть в глистах, и обращаются к врачу для обследования. Другие упоминают о том, что недостаточная гигиена или неправильное подмывание могут вызывать дискомфорт. Также родители отмечают, что в жаркую погоду или после активных игр у детей может возникать раздражение кожи. Важно помнить, что если проблема сохраняется, стоит обратиться к специалисту, чтобы исключить более серьезные заболевания и получить рекомендации по уходу. Забота о здоровье ребенка — это всегда приоритет.
https://youtube.com/watch?v=HXsLJSt54KQ
Диагностика
Поскольку энтеробиоз является заразным заболеванием, диагностику назначают детям, и родителям. Анализ кала в случае, является малоинформативным.
Для обнаружения остриц проводится соскоб ватным тампоном биоматериала со складок анального отверстия. Анализ сдается троекратно, без предварительной гигиены перианальной области.
Альтернативной является метод Грэхема. Вместо ватной палочки используется липкая лента. Ее прикладывают к месту, где чешется (задний проход). Прохождение диагностики у мужчин и женщин, не имеет отличий от детского варианта процедуры.
Лечение
Терапию энтеробиоза проводят в два этапа. Первично назначается прием сорбентов (Энтеросгель, Полисорб) для детоксикации организма. Далее назначаются специальные антипротозойные медикаменты.
К наиболее распространенным относятся:
Доза и схема приема определяется врачом, в зависимости от массы тела ребенка, и его индивидуальной переносимости лекарства.

Для облегчения ночного зуда, маленькому пациенту показаны вечернее клизмирование раствором пищевой соды (1/2 чайной ложки на стакан воды).
Обязательными условиями являются:
Профилактический курс антигельминтных препаратов назначается всем членам семьи, даже если у взрослых не чешется в заднем проходе, и отсутствуют другие симптомы паразитической инвазии.
Дисбиоз (дисбактериоз)
Заболевание, вызвано нарушением баланса патогенных микроорганизмов и полезных бактерий в кишечнике. Возникает, чаще всего, из-за погрешностей в питании малыша. Одним из симптомов болезни является интенсивное опорожнение кишечника (понос). Вследствие постоянного раздражения, у ребенка появляется зуд в прямой кишке. Другими признаками являются:
Диагностика и лечение
Для определения дисбиоза кишечника ребенку назначается копрограмма (анализ кала), и общий клинический анализ крови для определения степени воспалительного процесса.
Комплексная терапия дисбактериоза включает:

На протяжении всего терапевтического курса маленькому пациенту назначается диетический рацион (меню составляется согласно медицинской диете «Стол №5»).
Опрелости
В теплое время года у малыша, нередко, чешется попа внутри и снаружи, из-за опрелостей. Воспаление кожного покрова и кожных складок происходит вследствие нарушения терморегуляции.
Для ликвидации симптомов опрелости, родителям необходимо:
Проявления опрелости хорошо заживают на свежем воздухе. Для быстрого выздоровления ребенку будут полезны воздушные ванны.
Аллергические реакции
Нежная кожа малышей особенно подвержена аллергиям. Зуд в попе может возникнуть, как реакция на средства бытовой химии, используемые при стирке детского белья. В составе порошков, гелей, ополаскивателей содержатся ароматизаторы и другие химические наполнители. Эти вещества могут оказывать негативное влияние на кожные покровы и слизистые оболочки ребенка.
Для предотвращения подобных реакций, следует применять только специальные гипоаллергенные средства, предназначенные для обработки детских вещей.
При сильной аллергии, ребенку прописывают антигистаминные препараты для снятия симптомов:

Противогистаминные препараты обладают побочными эффектами. Важным моментом в лечении является точное соблюдение дозировки лекарств, назначенной доктором.
Трещины ануса
Основной причиной появления трещин в заднем проходе у детей является неправильное питание. Несбалансированный рацион вызывает проблемы с опорожнением кишечника.
Систематические обстипации (запоры) вызывают:
У ребенка чешется вокруг ануса из-за попадания в поврежденные участки микробов. При такой ситуации велик риск развития тяжелых инфекций анального отверстия и прямой кишки.
Для ликвидации трещи, прежде всего, необходимо скорректировать питание. В рационе должны преобладать:
Исключить из меню следует:
В качестве средств для наружного заживления разрывов применяют лекарственные травы (дубовая кора, ромашка). Отвары их сухого растительного сырья добавляют в таз с теплой водой, сажают туда ребенка. Медикаменты врач назначает индивидуально в каждом отдельном случае.
Грибок в кишечнике

Зуд в попе у ребенка вызывает микоз (грибок) кишечника. Возникновение заболевания вызвано нарушением микросреды организма, и энергичному размножению грибка рода кандиды.
Симптомы болезни:
Признаки заболевания схожи с дисбактериозом.
У ребенка наблюдаются:
В экскрементах могут присутствовать кровяные сгустки.
Для постановки диагноза используют методы лабораторной микроскопии:
Лечение назначает доктор, подбирая индивидуальную схему и препараты.

Терапия
Для ликвидации проявлений назначаются противомикозные лекарственные средства (Леворин, Нистатин), пробиотики и диетотерапия.
Проявление жжения и зуда у ребенка не должны оставаться без внимания. Кроме перечисленных заболеваний, могут быть обнаружены более серьезные патологии.
https://youtube.com/watch?v=CAvaZHGiMhk
Вопрос-ответ
Каковы основные причины зуда в области заднего прохода у детей?
Зуд в области заднего прохода у детей может быть вызван различными факторами, включая аллергические реакции на продукты питания, инфекции, такие как глисты, раздражение от подгузников или недостаточная гигиена. Также это может быть связано с кожными заболеваниями, такими как экзема или дерматит.
Как можно облегчить зуд у ребенка?
Для облегчения зуда важно соблюдать правила гигиены: регулярно мыть область заднего прохода теплой водой и мягким мылом. Также стоит избегать использования ароматизированных средств для ухода. Если зуд не проходит, рекомендуется обратиться к врачу для диагностики и назначения соответствующего лечения.
Когда следует обратиться к врачу при наличии зуда в заднем проходе у ребенка?
Если зуд сопровождается другими симптомами, такими как покраснение, отек, выделения или боль, или если он не проходит в течение нескольких дней, необходимо обратиться к врачу. Это поможет исключить серьезные заболевания и получить правильное лечение.
Советы
СОВЕТ №1
Обратите внимание на гигиену. Регулярное мытье области заднего прохода с использованием мягкого мыла и теплой воды поможет предотвратить раздражение и зуд. Убедитесь, что ребенок тщательно высушивает эту область после купания.
СОВЕТ №2
Проверьте на наличие паразитов. Зуд в заднем проходе может быть признаком наличия глистов, особенно у детей. Если вы заметили подобные симптомы, обратитесь к врачу для диагностики и лечения.
СОВЕТ №3
Следите за рационом питания. Убедитесь, что в рационе ребенка достаточно клетчатки, чтобы избежать запоров, которые могут вызывать дискомфорт и зуд. Включите в меню фрукты, овощи и цельнозерновые продукты.
СОВЕТ №4
Не игнорируйте аллергические реакции. Иногда зуд может быть вызван аллергией на моющие средства, туалетную бумагу или даже продукты питания. Обратите внимание на любые изменения в состоянии ребенка и проконсультируйтесь с врачом при необходимости.

